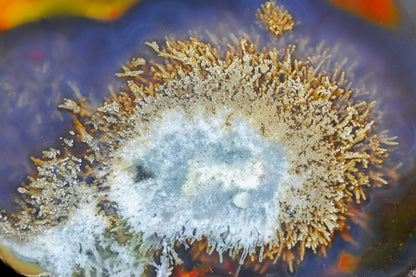
Argentina

1
/
of
6
Agatebay
Argentina
Argentina
Regular price
$375.00 USD
Regular price
$375.00 USD
Sale price
$375.00 USD
Shipping calculated at checkout.
Quantity
Optional
0 / 500
Couldn't load pickup availability
Condor - 69 mm - Pseudomorph
Shipping
Shipping
PAYMENT AND SHIPPING
The following conditions apply:
Shipping Conditions
Delivery is limited to the United States.
Shipping Costs (including statutory VAT)
Delivery Times
The delivery time is determined in this case by the item with the longest delivery time that you have ordered. As a rule, delivery within Germany takes place within 2-3 working days when shipped. The delivery time abroad is 2 - 30 days. Please note that no delivery takes place on Sundays and public holidays.
If you have any questions, you can find our contact details in the imprint.






We are currently out of office
You can subscribe to our Newsletter and we'll notify you as soon as our new collection is live.